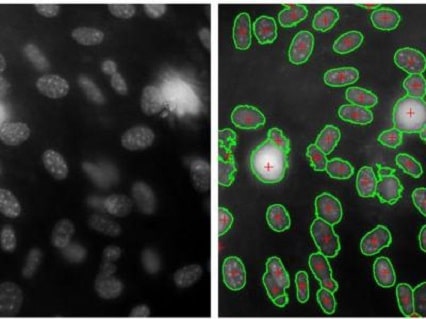
تحلیل داده های پزشکی، جدول، متن و تصویر 7 شناسایی سلول

داده ها دنبال گوش شنوا می گردند ...
تحلیل داده های پزشکی
داده های شما به صورت حرفه ای بر حسب حوزه و صنعت توسط متخصصین مورد تحلیل و ارزیابی قرار می گیرند.
تحلیل داده چیست؟
تحلیل داده فرایند فهمیدن، پاکسازی، آمادهسازی و تحلیل دادههاست که به منظور استخراج اطلاعات سودمند برای تصمیمگیری انجام میشود.تحلیل داده با نرم افزار
نرم افزارهای آماری همچون اکسل (EXCEL) و SPSS جزو قایل دسترس ترین نرم افزارها برای پردازش و تجزیه و تحلیل داده های جدولی هستند.تحلیل داده با پایتون و R
تحلیل داده با زبان های برنامه نویسی پایتون و R باعث اکتشاف بیشتر و کشف پترن در بین داده ها می شود. همچنین این زبان ها امکان بصری سازی و رسم نمودار را دارند.هوش سبز در اغلب دانشگاه های کشور وجود دارد






انواع پروژه های تحلیل داده
نظرات مشتریان هوش سبز
تحلیل داده های آزمایشگاهی برای شناسایی سلول های خونی توسط گروه هوش سبز برای نوشتن مقاله من بسیار کمک کننده بود.
مهین بابایی
تیم هوش سبز با حرفهایترین روشها دادههای تصویری را تحلیل میکنند. تجربه من با آنها بسیار مثبت بود.
سمیرا آقایی
خدمات بسیار مفید و کارآمدی هستند. با تحلیل دادههای متنی از اینجا به راحتی به نتایج دقیق و قابل اعتماد دست پیدا کردم.
علی کاشانی
بسیار خوشحالم که با هوش سبز آشنا شدم. تحلیل دادههای تصویری بسیار دقیق و حرفهای انجام میدهند.
نورا حسینی
پروژههای من با هوش سبز بسیار موفق بودند. خدمات تحلیل دادههای متن و جدولی آنها بسیار قابل اعتماد هستند.
سهیلا نادری
مشتری مداری و گزارش دهی هوش سبز بسیار عالی بود و در نوشتن پایان نامه ام بسیار کمک کننده بودند.